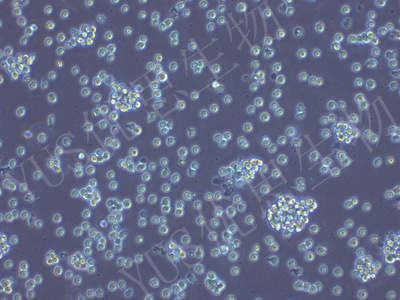
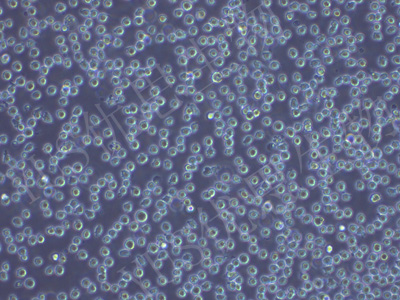

产品中心
产品中心
-
OCI-LY3 人弥漫大B细胞淋巴瘤细胞(STR鉴定)
货号:YLH160规格: 1*10^6 -

SK-HEP-1 人肝窦内皮细胞(STR鉴定)
货号:YLH161规格: 1*10^6 -

KATO III 人胃癌细胞(STR鉴定)
货号:YLH162规格: 1*10^6 -

NCI-H157 人非小细胞肺腺癌细胞(STR鉴定)
货号:YLH163规格: 1*10^6 -
AKATA EBV 转化淋巴细胞系(STR鉴定)
货号:YLH164规格: 1*10^6 -

SK-OV-3 人卵巢癌细胞(STR鉴定)
货号:YLH165规格: 1*10^6 -

A498 人肾癌细胞(STR鉴定)
货号:YLH166规格: 1*10^6 -

AGS 人胃腺癌细胞(STR鉴定)
货号:YLH167规格: 1*10^6 -

T-47D 人乳腺导管癌细胞(STR鉴定)
货号:YLH168规格: 1*10^6 -

HGC-27 人胃癌细胞(未分化)(STR鉴定)
货号:YLH169规格: 1*10^6 -

Capan-2 人胰腺癌细胞(STR鉴定)
货号:YLH171规格: 1*10^6 -

QSG-7701 人正常肝细胞(STR鉴定)
货号:YLH172规格: 1*10^6
在线咨询
Online consultation

关注微信公众号


